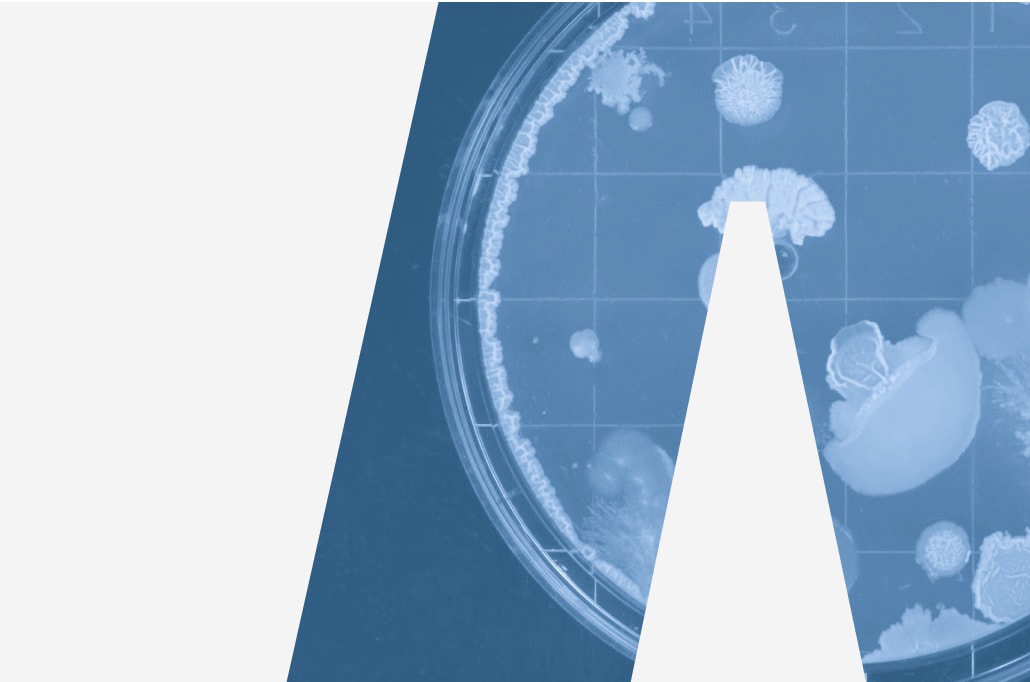

Federation of American Scientists
The Federation of American Scientists works to address global risks, advance science-based policies, and tackle contemporary issues like climate change, emerging technologies, and government capacity, ensuring scientific expertise shapes policymaking for a safer, more equitable future.
Our brief focused on refreshing FAS's visual identity to reflect its evolved approach to research and policymaking, which now emphasises timely, actionable, and ambitious Science & Technology ideas. With a shift towards action-oriented work and a commitment to shaping policy and driving societal change, the rebrand aims to align FAS’s visual presence with its dynamic growth and future aspirations.
This project centres around the universally recognisable delta symbol (Δ), which has long been associated with change, transformation, and progress. By incorporating this symbol into the rebrand, we aim to visually communicate FAS' commitment to driving meaningful change within the academic policy-making sector.
The solution is a brand that strikes a balance between modernity and legacy, presenting FAS as a forward-thinking organisation that appeals to a new generation of policy-makers, while maintaining the credibility and reputation it has built since its founding in 1946. This website was built in collaboration with our friends at TGHP.

- Future focused
- Considerate
- Relevant

The Delta Symbol



Typography


In Application




The FAS Website



Brand Guidelines
